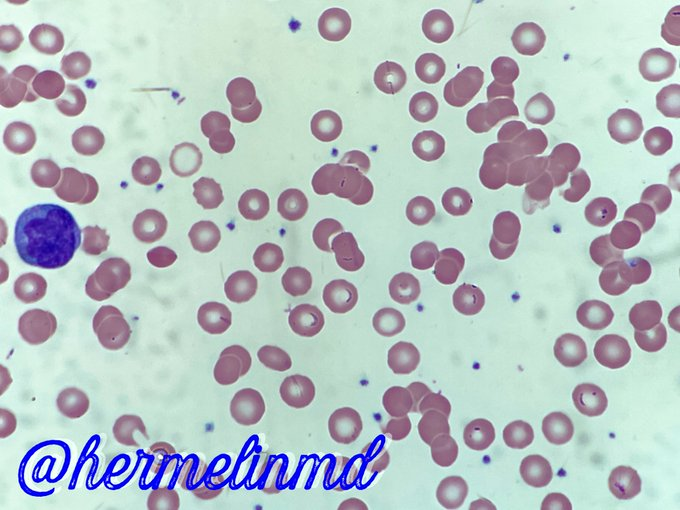

Justin Kreuter, MD
@kreutermd
Pathologist (transfusion & HLA) @MayoClinic |Tweets mine, not med advice| #HMIchat #HMIVirtual #Blooducation #LabMedicineRounds #CLEC2024
ID: 3214331029
http://bit.ly/KreuterMD 17-05-2015 18:10:23
11,11K Tweet
4,4K Followers
2,2K Following




Nice time with the #AABBChamps 🤩 #AABB24 AABB @AsapwariBapat Aaron D. Shmookler, MD, QIA^CM (he/him/his) Chloe, MLS(ASCP)ᴄᴍ,SBBᴄᴍ Nalan Yurtsever, MD Homayemem Weli-Numbere MD MSc PhD Drew Case Juan Vitelio Rodríguez, MD, FASCP 🇸🇻🩸 Dr. Vasiliki E. Kalodimou (@DrVKalodimou) Jasem Albasri





AABB is pleased to welcome Meghan Delaney, DO, MPH, chief of the division of pathology and laboratory medicine and director of transfusion medicine at Children's National Hospital 🏥, as AABB president for the 2024-25 year. Please join us in welcoming Dr. Delaney! #AABB24 bit.ly/4fb2Zj6


Top Influencers of #AABB24 👉 AABB Aaron D. Shmookler, MD, QIA^CM (he/him/his) Asawari #Asa Bapat (she/her) Nalan Yurtsever, MD Chloe, MLS(ASCP)ᴄᴍ,SBBᴄᴍ symplur.com/healthcare-has… via Symplur



Love being at #MayoGRIT2024 Mayo Clinic GRIT with my Mayo Clinic Labs colleagues in beautiful #LakeTahoe Maria Willrich, PhD #WomenInMedicine #WomenInLeadership



In the latest “How do I…?” feature in #Transfusion, authors from UT Southwestern Medical Center describe how they manage hyperhemolysis syndrome. Read the open-access feature: bit.ly/3AoFJzm


Save the date! AABB’s Global Transfusion Webcast returns at 10 a.m. ET on Wednesday, Nov. 13. Join Quentin Eichbaum, Daniela Hermelin, MD and a panel of guest experts to explore compatibility and pretransfusion practice. Learn more: bit.ly/40to7gg #Transfusion #BloodBanking